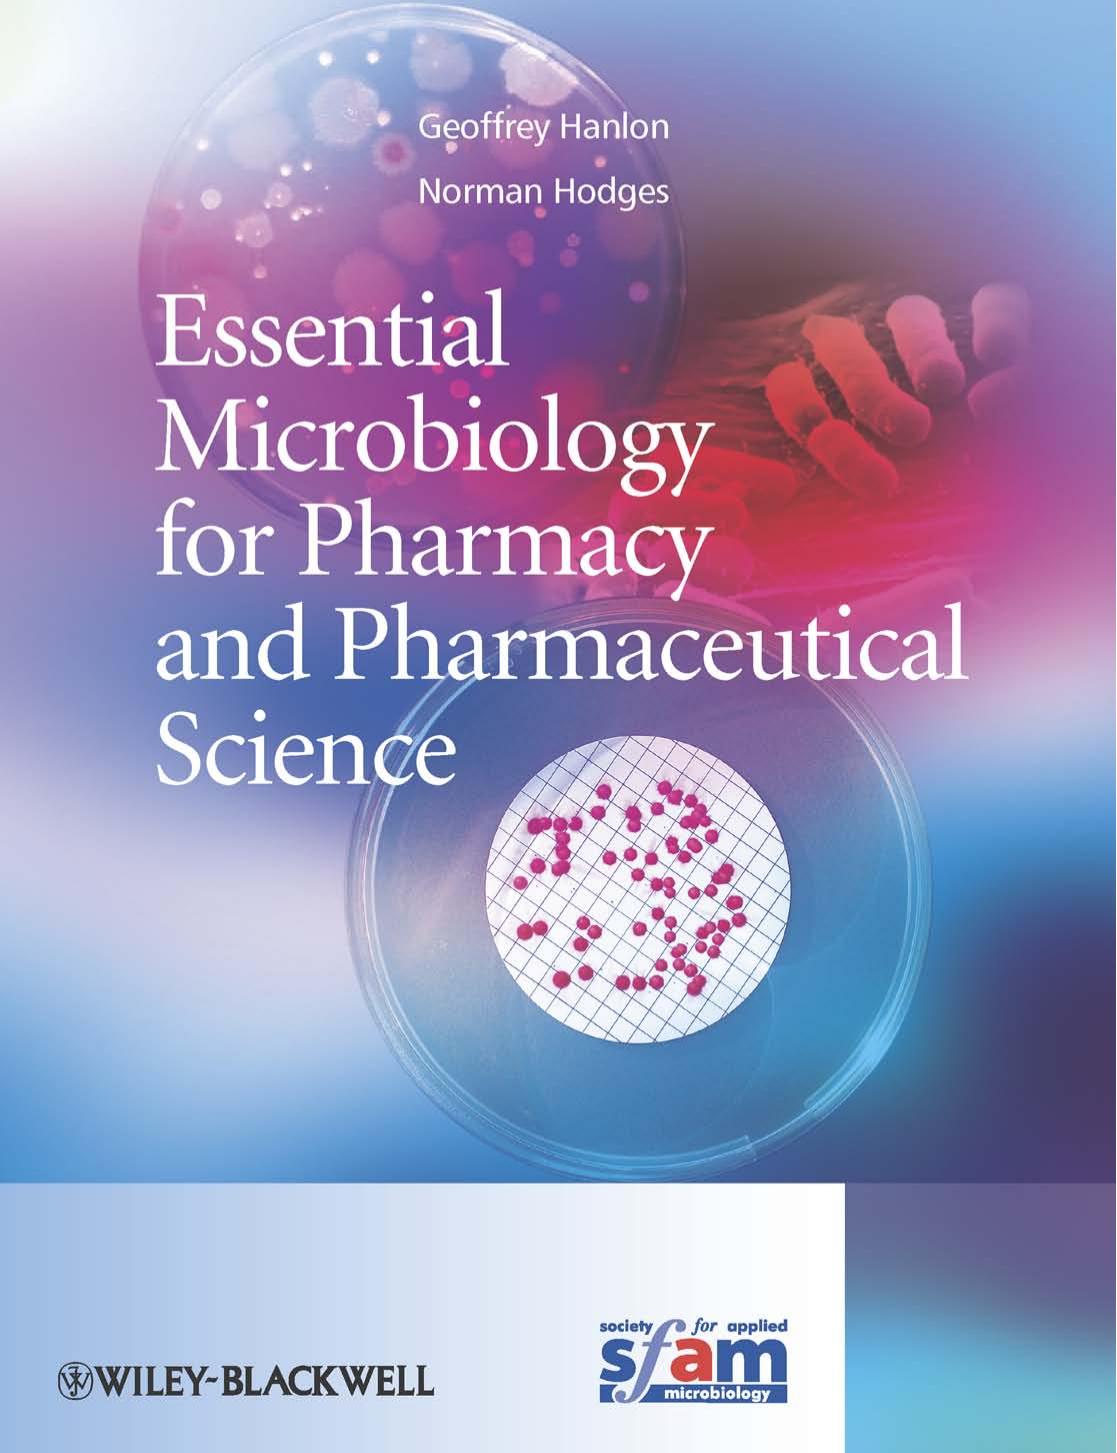

Essential Foundations of Economics 7th Edition by Robin Bade Michael Parkin - Wei Zhi
价格:25.00

Essential Guide to Acute Care,2nd Edition - Wei Zhi
价格:25.00

Essential Hypertension - Wei Zhi
价格:25.00

Essential Jazz 3rd Edition by Henry Martin & Keith Waters - Henry Martin & Keith Waters
价格:25.00

Essential Manual of 24 Hour Blood Pressure Management - Kazuomi Kario
价格:25.00

Essential Med Notes 2014 - Miliana Vojvodic, MSc & Ann Young, PhD
价格:25.00

Essential Medical Notes 2015 Comprehensive Review for USMLE and MCCQE - TONotes
价格:25.00
Essential Microbiology for Pharmacy and Pharmaceutical Science - Geoffrey Hanlon, Norman Hodges
价格:25.00

Essential Neuroscience, 3rd Edition by Siegel, Allan - Allan Siegel & Hreday N.Sapru
价格:25.00
总共 51668 条,分为5741页





